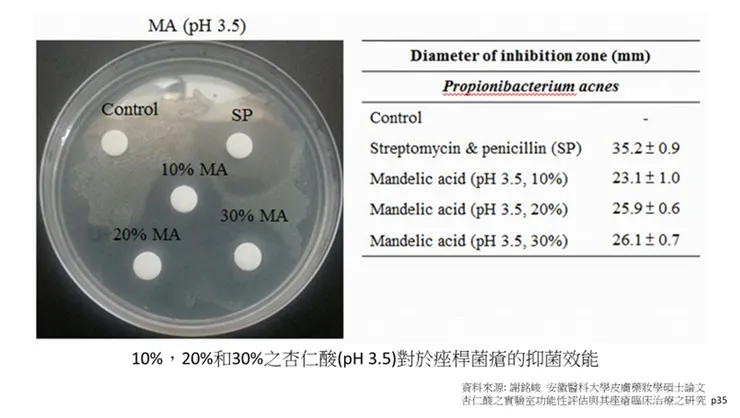
vocus|新世代的創作平台

《「謝銘峻 醫師 2022.7.30」》
# 杏仁酸是什麼?杏仁酸(mandelic acid,MA)是一種含8個碳原子的果酸,分子量為152.14 g·mol−1,較常用的第一代果酸--甘醇酸小。由於其化學結構式類似抗生素,因此它可以抑制多種細菌的增生。

# 杏仁酸功效的過往研究
之前有研究證實杏仁酸可用於治療泌尿道感染等相關疾病。另外,杏仁酸經過酸處理後形成杏仁酸聚合物(mandelic acid conconlation product,SAMMA),SAMMA具有良好的穩定性,安全性且已作為外用避孕藥,可以預防HIV病毒、HSV病毒、皰疹病毒和淋球菌。杏仁酸除了用於治療泌尿道感染等相關疾病,有專利指出,為了使人體對於藥物有更好的吸收,在製作過程中加入杏仁酸,使藥物變成人體較好吸收的鹽類。
杏仁酸烏洛托品(Mandelamine®,Methenamine mandelate)具有泌尿道抗菌劑的作用,在濃度為35g/100L到50g/100L的尿液裡面,顯示了對金黃葡萄球菌(Staphylococcus aureus)、變形桿菌(Bacillus proteus)、大腸桿菌(Escherichia coli)以及產氣桿菌(Aerobacter aerogenes)有很好的抑製作用。
然而,關於杏仁酸作為一種新興的果酸添加於藥妝品來進行皮膚改善的報導仍屬罕見。有文獻指出,杏仁酸治療痤瘡桿菌感染後引起的色素沉澱效果良好,且在臨床上已有使用水楊酸-杏仁酸換膚的相關治療。
# 杏仁酸在皮膚科學上的研究
Mark B 和Taylor MD通過長達三年多的時間對1100位患者進行使用杏仁酸改善痤瘡、皮膚皺紋、黃褐斑的測試,得出無論是杏仁酸單獨使用,或者和維他命C分階段使用對於皮膚改善都具有多重功效,包括抗菌性,痤瘡的治療以及皮膚紋理改善。然而,與羥基乙酸相比,杏仁酸不僅與羥基乙酸一樣對皮膚有良好的抗老化作用,而且對深色的黑色素沉澱具有良好的效果。另外,杏仁酸能夠避免雷射換膚後感染革蘭氏陰性細菌。
根據2014謝銘峻醫師的皮膚科藥妝學碩士論文內的研究試驗,杏仁酸(pH3.5)具有抑制蘑菇酪胺酸酶的活性,且隨著作用濃度愈高,抑制效果愈佳。
延伸閱讀:杏仁酸功效有哪些?5大最完整「杏仁酸」介紹,粉刺清除一次看

對於B16細胞的黑色素生成抑制方面,測試結果顯示pH3.5和pH7.0的杏仁酸對黑色素生成的抑制率分別為42.6%和39.7%。
在自由基的清除方面,實驗結果顯示杏仁酸(pH3.5)隨作用濃度增加,具有顯著清除DPPH·自由基及超氧陰離子(O2·-)的效能。
在膠原蛋白的刺激增生方面,可以發現5%和10%之杏仁酸均可以有效的促進膠原蛋白增生。

# 杏仁酸的抗菌功效
在杏仁酸的抗菌方面,結果顯示杏仁酸具顯著抑制痤瘡桿菌、大腸桿菌、金黃色葡萄球菌和綠膿桿菌生長之作用。
杏仁酸作用於痤瘡桿菌之抑菌效果:利用紙錠擴散試驗評估杏仁酸抑制痤瘡桿菌(Propionibacterium acnes)的效果,並使用市售的抗生素(Streptomycin & penicillin,SP)進行比較。結果如圖顯示,10%,20%和30%之pH1.9之杏仁酸對於痤瘡桿菌抑菌圈的直徑分別為20.9 mm,26.9 mm和30.8 mm,其最高濃度點(30%)之效果相近於抗生素的35 mm。圖18顯示,10%,20%和30%之pH 3.5之杏仁酸對於痤瘡桿菌抑菌圈的直徑分別為23.1 mm,25.9 mm和26.1 mm,其最高濃度點(30%)之效果相近於抗生素的35 mm。
# 杏仁酸對痤瘡(青春痘)臨床測試
而針對不同分期的痤瘡患者,臨床使用杏仁酸的治療結果顯示杏仁酸對各個分期的痤瘡患者都具有相當不錯的改善效果。
在謝銘峻醫師的杏仁酸藥妝學碩士論文中針對625例不同分期的痤瘡患者,按照既定的治療模式,全部案例都使用濃度為10%之杏仁酸。輕度患者的平均改善率大約在62%,自覺有改善的病患比例為86%。中度患者的平均改善率約在75%,而自覺有改善的病患比例為93%。重度患者的平均改善率大約為70%,自覺有改善的病患比例甚至高達86%。
在副作用方面,有5.7%的患者出現輕微刺痛感,2.8%的患者有輕微的局部肌膚泛紅,主要都是出現在中度以上治療的患者。


# 總結
總合來說,杏仁酸是親脂性果酸,與皮膚的親和力高,容易滲透角質層並深入皮膚發揮作用,不僅針對油性膚質和痤瘡膚質能達到抗菌、改善阻塞等良好效果,對於日光性老化、尤其是黑色素沉著,包括膚色不均、暗沉、黑斑、雀斑、發炎後色素沉澱等等,在臨床上,均有明顯的效果性。
文章出處:www.dr-hsieh.com

















